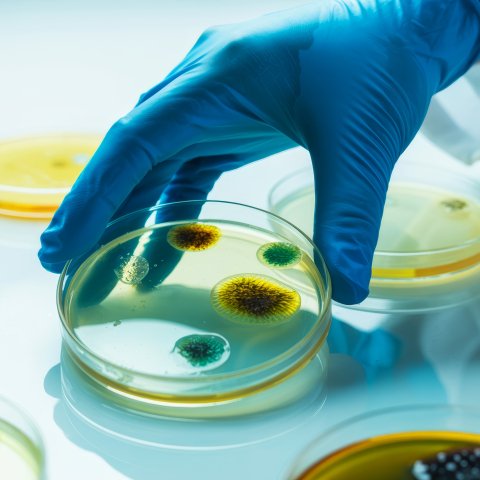

Manufacturer of High-Precision Reticles and Photolithographic Components
Innovation, Quality, and Support
Is at the heart of every product we make.
Shop for our extensive range of Reticles, TEM Grids, Apertures and Precision Photolithographic Products on Glass, Film and in Metal Foil.

Microscope Eyepiece Reticles

Stage Micrometers, Calibration Scales / Grids

TEM Grids (Specimen Support Grids) & Thin Film Coated Grids

Optical Resolution Charts

Precision Apertures

Counting Chambers

Inspection Instruments & Magnified Scales

Custom Optics
White Glass Micropatterns

Individually DMC Coded TEM Grids

Film Cover Slips and Film Reticles

Photomasks